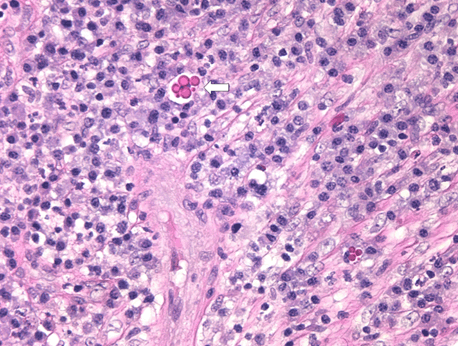

|

|
 |
|
Case Report
| ||||||
| Multiple Intracranial Inflammatory Pseudotumors | ||||||
| Christopher C. Gillis1, John A.C. Maguire2, Charles S. Haw3 | ||||||
|
1University of Nebraska Medical Center, Division of Neurosurgery, Omaha, NE.
2University of British Columbia Department of Anatomical Pathology, Vancouver, B.C.. 3University of British Columbia Department of Surgery Division of Neurosurgery, Vancouver, B.C. | ||||||
| ||||||
|
[HTML Abstract]
[PDF Full Text]
[Print This Article]
[Similar article in Pumed] [Similar article in Google Scholar] 
|
| How to cite this article |
| Gillis CC, Maguire JAC, Haw CS. Multiple Intracranial Inflammatory Pseudotumors. Int J Case Rep Images 2015;6(8):488–492. |
|
Abstract
|
|
Introduction:
Inflammatory pseudotumor is a rare intracranial lesion. Reports of multiple intracranial inflammatory pseudotumors are very rare.
Case Report: A 68-year-old female presented with left hemiparesis and sensory neglect and was found to have two homogeneously enhancing lesions on computed tomography (CT) scan near the right rolandic area. The larger of the two lesions was resected with the presumed radiographic and intraoperative diagnosis of meningioma. Pathology demonstrated inflammatory pseudotumor. She re-presented eight months postoperatively with both progression of the remaining lesion and a de novo lesion. Biopsy was done which reaffirmed the diagnosis. The patient was tried on high dose steroid, giving radiographic but not clinical improvement. Treatment was intensified to methotrexate which gave both clinical improvement and radiographic improvement. The patient was then treated with methotrexate giving symptomatic improvement. Conclusion: The differential for extra-axial lesions should include inflammatory pseudotumor. The best treatment for this disease process has not been determined. Surgical resection and steroid therapy may help temporize symptoms and provide a diagnosis but in the case of multiple lesions this likely represents a diffuse intracranial process requiring chemotherapy. | |
|
Keywords:
Central nervous system, Chemotherapy, Craniotomy, Inflammatory pseudotumor, Neoplasms
| |
|
Introduction
| ||||||
|
Inflammatory pseudotumor (IPT) is a rare intracranial entity with approximately 50 previously reported cases of isolated intracranial lesions [1] [2] [3]. There have been six previous case reports of multiple intracranial lesions, but no reports of new intracranial lesions arising after initial treatment [1]. The original description of an IPT was in the lung by Bahadori and Liebow in 1973 [4]. Since that time, this condition has also been described in various organs including the heart, stomach, pancreas, spleen, kidney, thyroid, larynx, tonsils and retroperitoneum. Intracranial lesions are histologically different and behave differently than those found elsewhere in the body [2] [5] [6]. They are characterized by a non-neoplastic proliferation of polyclonal plasma cells with lymphocytes, eosinophils, and histiocytes also present in varying proportions [6]. This polyclonal distribution of plasma cells is in contrast to plasmacytoma: a monoclonal and malignant proliferation of plasma cells. The best treatment for IPT remains undetermined. Previous reports have chosen observation, steroid treatment, chemotherapeutic treatment, radiotherapy and surgical resection all with good clinical results [1] [2] [7][8]. There is one reported cases of inflammatory pseudotumor unresponsive to primary therapy and requiring chemotherapeutic treatment [6]. We present a very unique case of multiple intracranial lesions on presentation that did well originally with resection, but then had an additional lesion arise in a new intracranial location following resection with interval enlargement of a non-resected lesion, that went on to fail steroid treatment and ultimately responded to systemic chemotherapy. | ||||||
|
Case Report
| ||||||
|
A 68-year-old female presented with a history of multiple falls. She was dragging her left foot and gait instability had progressed over a period of 2–3 months. Physical examination revealed mild left hemiparesis with a pronator drift of the left arm, left sensory neglect, and slight slurring of her speech. No papilledema was present. Computed tomography (CT) scan with and without intravenous contrast was performed. The imaging showed two lesions, one overlying the right motor cortex near the vertex and a smaller lesion located more anteriorly (Figure 1). The lesions enhanced homogenously with contrast, were hyperattenuating on plain CT, and measured 3.5 cm (rostral to caudal) x 1.9 cm (medial to lateral), and 1.5 cm x 0.7 cm. There was associated vasogenic edema, effacement of the sulci in the area of the lesions and 2 mm of midline shift to the left. The lesions appeared extra-axial. There was no associated hyperostosis or evidence of a dural tail. The differential based on the imaging was dural-based metastases, lymphoma, or meningioma although the findings were thought to be atypical of these diagnoses. Given the features of meningioma on the CT scan, MRI scan was not performed. The recommended treatment was resection for pathologic diagnosis and alleviation of symptoms. With a presumed diagnosis of meningioma, only the lesion over the motor strip was chosen for resection, with the clinical hemiparesis suggesting it was the symptomatic lesion. At craniotomy, the tumor was palpable through the dura. There was no associated hyperostosis on the bone flap, and the tumor was clearly extra-axial and had the appearance of a meningioma therefore no frozen section was sent. During the operation a reddish membrane was noticed in the subdural space in the area of the lesions which was thought could represent tumor and was removed. Pathological examination of the lesion demonstrated inflammatory pseudotumor and portions of the dura were also infiltrated by inflammatory cells. The inflammatory mass consisted of intense infiltrates of plasma cells (Figure 2), Langerhans cells, and lymphoid cells with polymorphonucleocytes surrounded by B lymphocytes in localized areas. Russell bodies were noted to be present (Figure 3). Osseous metaplasia was present and there was definite focal infiltration into the brain parenchyma by the inflammatory process. The diagnosis was based on the exclusion of infectious cause. On immunohistochemical stains, cluster of differentiation antigen (CD) 1a, CD3, CD5 and CD45 were noted to be positive demonstrating the presence of T cells. CD20 specific for B cells and CD30 a marker for active T and B cells stained positive. S-100 protein also stained positive which is a marker for cells derived from the neural crest including Langerhans cells and Dendritic cells. CD138 was positive, indicative of the presence of plasma cells and there was positive staining for both kappa and lambda suggesting polyclonality ( (Figure 4); sampling of immunohistochemical staining). There was no evidence of amyloid deposition. Stains for bacteria, fungi or acid-fast bacilli were all negative. A negative stain for spirochetes was also performed. The final diagnosis of inflammatory pseudotumor was favored due to the large component of plasma cells. Postoperatively, the patient did well for about eight months until she developed worsening left hemiparesis and personality changes. Literature suggested good results with steroid treatment, she was maintained on dexamethasone post-operatively at 4 mg BID but had progressed. On repeat CT scan (Figure 5), the non-resected right frontal lesion had increased in size and there was a new left sided fronto-parietal lesion, a location without any previous evidence of lesion. Given this 'de novo' lesion and the lack of any previous reports of an inflammatory pseudotumor arising de novo in previously treated patients, biopsy of the right frontal lesion was performed to ensure the correct pathologic diagnosis. The biopsy pathology continued to demonstrate inflammatory pseudotumor. A nuclear medicine gallium scan showed mild activity intracranially that was thought to correspond to the right frontal lesion or possible postoperative change. The scan did not demonstrate sarcoidosis, systemic inflammation or any other gallium- avid lesions. High dose steroid treatment for 5 days and long-term treatment with regular prednisone was initiated. The lesions improved on radiology, but the patient remained clinically unwell. The patient was then referred to the medical oncology service and methotrexate treatment was initiated resulting in symptomatic improvement, leading to the patient returning to independent living. | ||||||
|
| ||||||
| ||||||
|
| ||||||
|
| ||||||
|
| ||||||
|
Discussion
| ||||||
|
The resemblance of inflammatory pseudotumor (IPT) to meningioma has previously been described noting they can radiographically, clinically and histiologically mimic this classic extra-axial lesion [4]. Radiographically, IPT is classically T2 hypointense with intense homogeneous contrast enhancement [7]. Localization can be extra-axial, intra-axial or both [7] [8][9] [10]. Depending on the specific appearance the differential can include meningioma, primary central nervous system (CNS) lymphoma, plasmacytoma, tuberculoma, sarcoidosis, and Wegener's granulomatosis [3] [7] [8] [9] [10] [11] [12]. There are reported cases of atypical appearance of IPT resembling malignant brain tumor as well, having T2 hyperintensity and ring-enhancing appearance [3]. IP Tremains a very rare entity with approximately 50 previous cases reported of a single intracranial lesion, of which the majority was extra-axial in location [3]. There are only six previously reported cases of multiple intracranial lesions [1]. The presence of Epstein-Barr virus has been noted in many inflammatory pseudotumors, leading to the theory that the virus may play some role in etiology. Literature on these lesions generally points to the belief in an infectious or autoimmune etiology. This would be consistent with the EBV findings, but not all cases have shown to be EBV positive [1]. At this point the pathogenesis of IPT remains unclear. There is some suggestion it may result from a general imbalance of the immune system and supporting this hypothesis, there is an association of IPT with Crohn's disease [11]. Treatment for these lesions ranges from surgical resection, to chemotherapeutic agents, radiotherapy and simply the use of steroids. The most effective treatment for these lesions has not been determined. The most common treatment is complete excision, when possible. Generally, inflammatory pseudotumors are thought to be benign but the prognosis is unknown given the limited data available. Flannery et al. [2] have described the use of low dose steroids to manage a subtotally resected lesion with resolution of the disease. There is a case of recurrence following treatment with radiotherapy and steroids; the recurrence was treated with methotrexate and 6-mercaptopurine [6]. A more recent case was successfully treated using the anti-CD20 treatment Rituximab [7]. The longest follow-up period was 14 years in one patient illustrating four recurrences treated with 2 craniotomies, 3600 cGyradiation therapy and then two courses of steroid treatment [8]. Authors found that following the erythrocyte sedimentation rate (ESR) was useful in following recurrent disease; correlating along with both lesion recurrence and treatment [8]. | ||||||
|
Conclusion
| ||||||
|
We conclude that inflammatory pseudotumor should be in the differential diagnosis for meningioma, based on similar radiographic and intra-operative findings to meningioma. Further, in the case of multiple intracranial lesions the process is non-focal and thus surgery has a limited role outside of pathologic diagnosis, with a larger role for systemic therapy such as steroid treatment and/or chemotherapy. | ||||||
|
References
| ||||||
| ||||||
|
[HTML Abstract]
[PDF Full Text]
|
|
Author Contributions
Christopher C. Gillis – Substantial contributions to conception and design, Acquisition of data, Analysis and interpretation of data, Drafting the article, Revising it critically for important intellectual content, Final approval of the version to be published John A.C. Maguire – Analysis and interpretation of data, Revising it critically for important intellectual content, Final approval of the version to be published Charles S. Haw – Analysis and interpretation of data, Revising it critically for important intellectual content, Final approval of the version to be published |
|
Guarantor of submission
The corresponding author is the guarantor of submission. |
|
Source of support
None |
|
Conflict of interest
Authors declare no conflict of interest. |
|
Copyright
© 2015 Christopher C. Gillis et al. This article is distributed under the terms of Creative Commons Attribution License which permits unrestricted use, distribution and reproduction in any medium provided the original author(s) and original publisher are properly credited. Please see the copyright policy on the journal website for more information. |
|
|